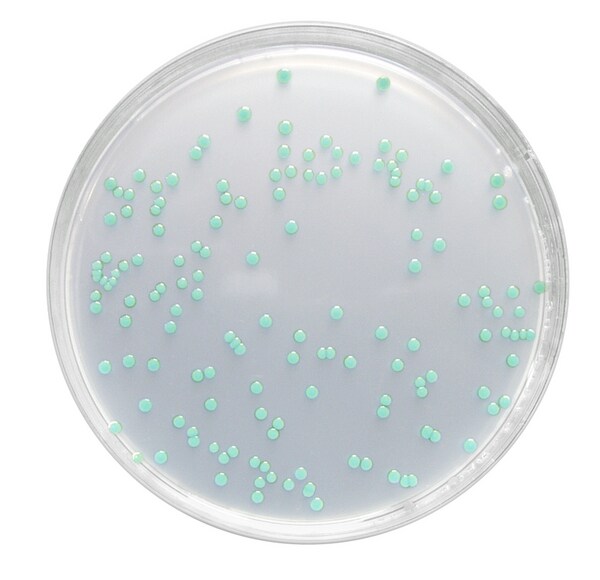
1004270500.jpg

* Imagem meramente ilustrativa
CHROMOCULT LISTERIA SELETIVO AGAR (ALOA) - ISO 11290 MERCK - EMB 500G
Modelo: 1004270500
R$ 1.248,26
ou até 3x de R$ 416,09 sem juros
Economize 5% no PIX: R$ 1.185,85
ou 3,5% no boleto: R$ 1.204,57
Calcular Frete
Descrição
CHROMOCULT LISTERIA SELETIVO AGAR BASE (ALOA) MERCK
DE ACORDO OTTAVIANI e AGOSTI (ISO 11290)
REND. 35g EM 476ml
Embalagem 500g.
Meio cromogênico Chromocult Listeria Selective Agar para detecção de Listeria monocytogenes. O meio corresponde ao Agar Listeria acc. to Ottaviani and Agosti (ALOA) de acordo com recomendações da ISO 11290 (2004) e FDA/BAM (2003).
Excelente qualidade técnica.
Composição de acordo com ISO 11290.
Meio na forma granulada, onde com a formação de menos pó, reduz significativamente a inalação de substâncias tóxicas.
Composição típica (g / litro):
Peptona de carne 18,0; peptona de caseína, 6,0; extrato de levedura 10,0; piruvato de sódio 2,0; glucose 2,0; glicerofosfato de magnésio 1,0; sulfato de magnésio 0,5, cloreto de sódio 5,0, cloreto de lítio 10,0; dissódico fosfato de hidrogenio de 2,5, 5-bromo-4-cloro-3-indolil-ß-D-glucopiranósido 0,05; ágar-ágar 13,0.
O Meio e Preparado a Partir do Agar Base e da Adição posterior dos Dois Suplementos:
Código Produto
1.00427.0500 Chromocult Listeria Selective Agar (70 g/L)
1.00432.0010 Listeria Agar Selective Supplement (10 vials para preparação de 5 litros de Listeria Selective Agar) - NÃO INCLUSO
1.00439.0010 Listeria Agar Enrichment Supplement (10 vials para preparação de 5 litros de Listeria Selective Agar) - NÃO INCLUSO
